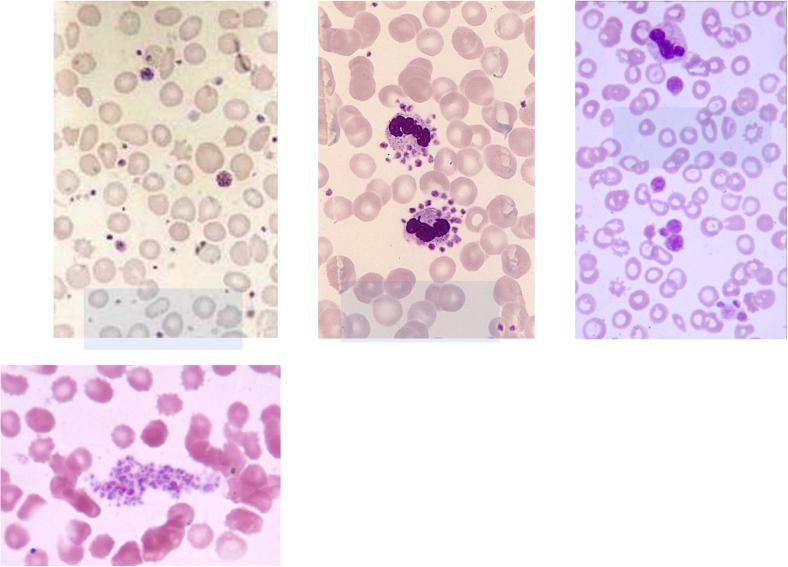

Материал: клинический+анализ+крови+2

Мегакарио(тромбоцито)поэз
Мегакариобласт
Промегакариоцит
Мегакариоцит
Тромбоциты
Осуществляется в костном мозге.
Мегакариобласт морфологически заметно отличается от других бластов, особенно если видна отшнуровка тромбоцитов. В мазках костного мозга здоровых людей.
Промегакариоциты значительно крупнее, часто имеют двудольчатое (двулопастное) ядро.
Зрелые мегакариоциты – самые крупные клетки системы крови, за исключением некоторых многоядерных макрофагов. В их цитоплазме часто хорошо различаются уже сформированные тромбоциты, которые покрываются гликокаликсом и могут свободно отделяться от цитоплазмы мегакариоцита.

Тромбоциты хорошо видны в цитоплазме мегакариоцита

Схема выхода тромбоцитов из паренхимы костного мозга в кровь
Мегакариоциты образуют псевдоподиеподобные выпячивания цитоплазмы, которые проникают в просвет синусоидов костного мозга и текущая кровь смывает тромбоциты. Сегментация ядер мегакариоцитов позволяет некоторым из них проникать целиком в кровь. В лёгких они не могут пройти из артериолы в венулу и, останавливаясь в просвете артериолы, продолжают образование тромбоцитов.
Причины ложных тромбоцитопений
Анизоцитоз
тромбоцитов
Агрегация тромбоцитов
Гигантизм
тромбоцитов
Сателлитизм
тромбоцитов
Во всех этих случаях не все тромбоциты воспринимаются анализатором: прилипшие к нейтрофилу (сателлиты) и самые мелкие («мусор») не учитываются, крупные идут в подсчёт вместе с эритроцитами, тромбоциты в составе агрегатов не узнаются и не идут в счёт. При тромбоцитопении без признаков кровоточивости вначале надо исключить её технические причины.
Пример ошибки определения количества тромбоцитов при крупнотромбоцитарной тромбоцитопатии
Пациентка Н.А.А.,22 года
•Заболеваниепроявилось в раннем детстве, носовые кровотечения, тромбоцитопения
•Диагноз ИТП, лечениеГКС, спленэктомияв возрасте 3 лет
•Периодическое курсовое лечение ГКС не реже одногораза в 2 года
•Эффекта в плане прироста тромбоцитов не было
•В настоящее время месячные по 7-10 дней, редко
– по 5, других кровотечений практически нет
•Много лет ЖДА, периодически, явно недостаточно,лечится препаратами железа